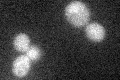
YER175C
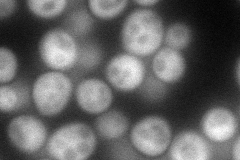
YER175C
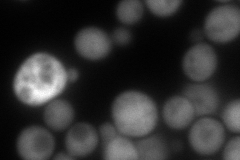
YER175C
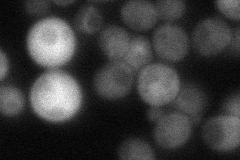
YER175C

View description
Trans-aconitate methyltransferase, cytosolic enzyme that catalyzes the methyl esterification of 3-isopropylmalate, an intermediate of the leucine biosynthetic pathway, and trans-aconitate, which inhibits the citric acid cycle
Localization:
Intensity:
Fold change:
Significance:
-
C’ GFP library in SD
cytosol23.04 -
N' NOP1pr-GFP in SD
cytosol104.71 -
N' TEF2pr-mCherry in SD
cytosol163.59 -
N' NATIVEpr-GFP in SD
cytosol35.5146 -
N' TEF2pr-VC and Cyto-VN in SD

#N/A0 -
C’ GFP library in SD+DTT

cytosolN/AN/ANo -
C’ GFP library in SD+H2O2

cytosolN/AN/ANo -
C’ GFP library in Starvation Media

technical problem0N/AYes -
C’ GFP library on the background of Pup2-DaMP

cytosol -
C’ GFP library on the background of CCT mutant

cytosolN/AN/ANo
